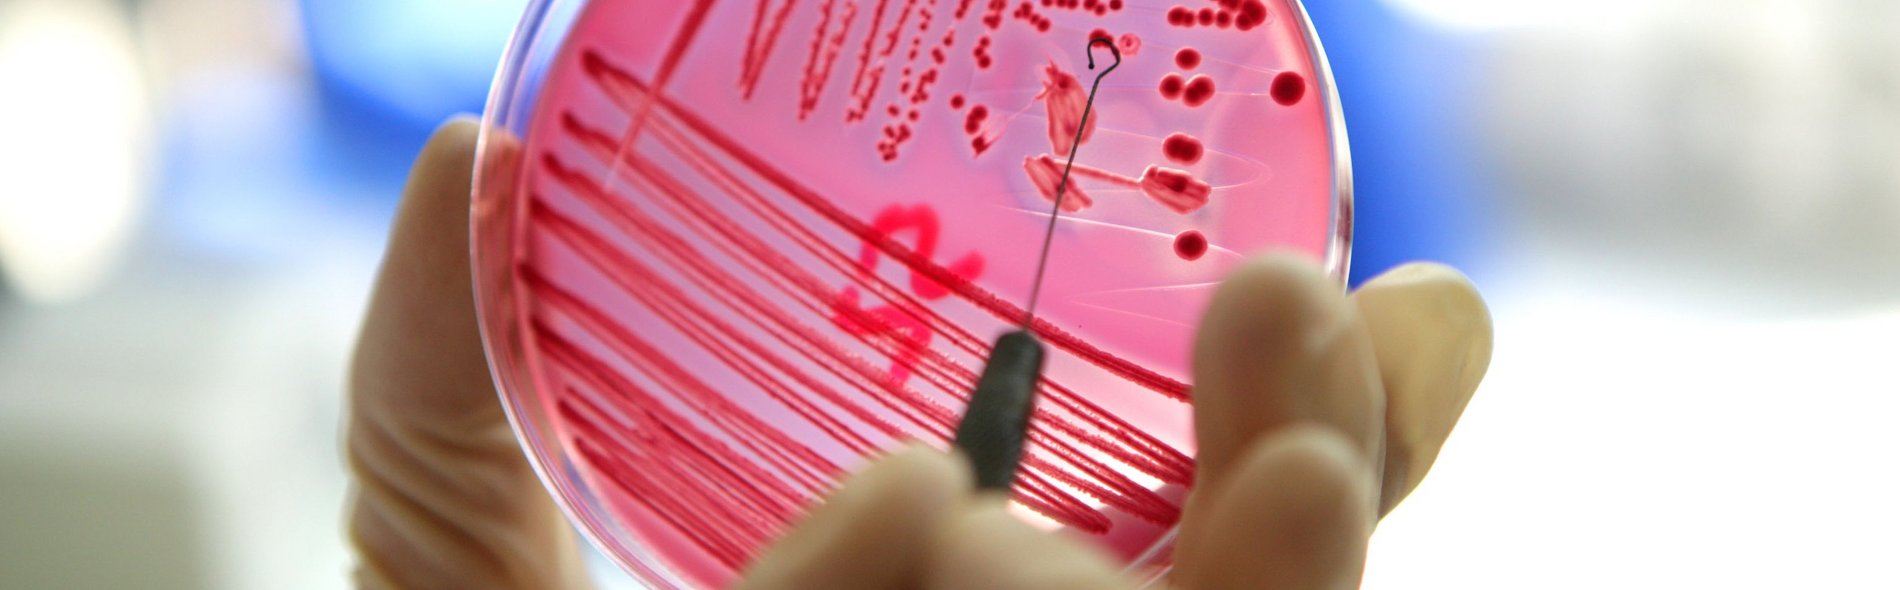
Hand, die eine Petrischale mit rotem Agar hält, der mit Bakterien durchzogen ist. Mit einer Schleifenzange wird eine Probe entnommen, was einen wissenschaftlichen, experimentellen Eindruck vermittelt.

Was bedeutet MRGN?
Im Darm – und auch auf der Haut sowie Schleimhaut des Menschen – befinden sich zahlreiche unterschiedliche Bakterien. Einige dieser Bakterien fasst man aufgrund ihres Aussehens unter dem Mikroskop als gramnegative Stäbchen-Bakterien zusammen. Zu diesen gehören Darmbakterien (Enterobakterien) und andere Keime (zum Beispiel Acinetobacter baumannii und Pseudomonas aeruginosa), die gegen viele Antibiotika widerstandsfähig werden können. In einem solchen Fall werden sie MRGN (multiresistente gramnegative Stäbchen-Bakterien) genannt. Man unterscheidet 3MRGN und 4MRGN aufgrund der unterschiedlichen Resistenzen gegen Antibiotika. 4MRGN-Bakterien sind resistenter als 3MRGN-Bakterien.
Wie erwirbt man die MRGN-Bakterien?
Die 3MRGN werden inzwischen bei vielen gesunden Menschen in der Allgemeinbevölkerung gefunden, oft auch nach Auslandsaufenthalten oder nach Antibiotikabehandlungen. Die 4MRGN sind eher Folge einer schweren Erkrankung mit längeren und verschiedenen Antibiotikabehandlungen.
Wie werden MRGN-Bakterien übertragen?
Hohe Konzentrationen an MRGN-Bakterien können im Stuhl und in bestimmten Fällen im Urin, manchmal auch in offenen Wunden vorhanden sein. Acinetobacter baumannii und Pseudomonas aeruginosa können sich darüber hinaus auch auf der Haut und Schleimhaut befinden. Von dort werden sie im Wesentlichen über die Hände auf andere Menschen übertragen. Eine Übertragung ist möglich, wenn besiedelte Wunden nicht abgedeckt sind oder die Regeln der Basishygiene nicht ausreichend beachtet werden.
Wann wird es für Ihre Gesundheit problematisch?
Eine bloße Besiedelung des Darms oder der Haut mit diesen Bakterien ist für gesunde Menschen und Kontaktpersonen nicht gefährlich. Die Mehrzahl der Bakterien ist für die Gesundheit des Menschen wichtig, einzelne können der Gesundheit aber schaden. Problematisch für Ihre Gesundheit kann es werden, wenn MRGN-Bakterien entweder aus dem Darm oder von der Haut in Wunden, in die Blutbahn oder in andere Körperregionen eindringen und krank machen. Bei diesen Erkrankungen kann die Notwendigkeit bestehen, spezielle Antibiotika einzusetzen.
Wann soll behandelt werden?
Nur bei einer Erkrankung mit Krankheitssymptomen wird Ihr Arzt oder Ihre Ärztin eine spezielle Behandlung mit einem der wenigen noch wirksamen Antibiotika durchführen. Eine Behandlung von MRGN-Bakterien ohne Krankheitssymptome ist nicht erforderlich. Eine „Darmsanierung“ ist nicht möglich.
Welche besonderen Maßnahmen müssen durchgeführt werden?
Im Krankenhaus
Die Händedesinfektion ist besonders wichtig, um eine Weiterverbreitung der Keime zu vermeiden. Patient:innen mit 4MRGN werden in der Regel in allen Bereichen des Krankenhauses isoliert. Patient:innen mit 3MRGN werden nur in besonderen Bereichen, in denen es durch die Art der Behandlung besonders leicht zu Infektionen kommen kann (zum Beispiel Intensivstationen oder Krebsstationen), isoliert.
Falls Ihr Arzt eine Isolierung angeordnet hat,
- dürfen Sie Ihr Zimmer nur nach Absprache mit dem Personal verlassen,
- müssen sich Besucher:innen vor Betreten des Zimmers beim Personal melden und bestimmte hygienische Maßnahmen befolgen,
- trägt das Personal zur Vermeidung von Übertragungen auf weitere Personen bei Ihrer Behandlung Schutzkleidung (zum Beispiel Kittel, Handschuhe).
Außerhalb des Krankenhauses
Waschen Sie sich sorgfältig und häufig die Hände und befolgen Sie die Regeln der persönlichen Hygiene. Dann ist das Übertragungsrisiko gering. Führen Sie ein normales Leben! Informieren Sie Ihre weiterbehandelnden Ärzt:innen und Pflegenden darüber, dass bei Ihnen MRGN-Bakterien festgestellt wurden.
Welches Ziel wird angestrebt und wie wird dieses erreicht?
Oberstes Ziel ist, die Weiterverbreitung von MRGNBakterien vor allem auf andere Menschen zu verhindern. Die wichtigste und gleichzeitig einfachste Maßnahme ist dabei eine korrekte Hände-Hygiene!